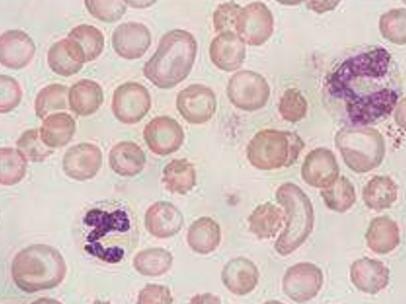

资讯
疾病资讯
-
来源:justone 2018年01月05日
女性盆腔是盆腔炎的症状之一,而盆腔炎是妇科常见的疾病,它是一种炎症疾病,对女性身体伤害比较严重。当女性出现盆腔疼痛症状时,要及时到医院确诊,当确诊为盆腔炎就
-
来源:sunny 2018年01月09日
慢性盆腔炎是一种非常顽固的女性妇科疾病,病程时间比较长,如果没有经过及时医学手段治疗的话,通常会引起更严重的连带反应。一、常见症状:患者初期会感觉不到身体
-
来源:sunny 2018年01月03日
通常患有慢性盆腔炎的女性通常症状不会太明显,有些患者仅仅会出现低烧,容易犯困,小腹疼痛等,常常会被误以为是感冒,肠胃不适,如果不及时就医诊断,很容易让病情进一
-
来源:tmsdzafd 2018年01月03日
大多数人三种支原体生殖道感染经常会发现感染两种:解脲支原体和人型支原体。对于解脲支原体和人型支原体,这种致病性仅在生殖器分泌物或尿液的10p4ucc/ml以上表达
-
来源:tmsdzafd 2018年01月03日
历史上口服四环素至少7天已经成为由于人为原因引起的泌尿生殖感染的首选药物,但是由于核糖体修饰引起的抗性现在发生在20-40%的分离物中。2000年至2004年间在美国
-
来源:tmsdzafd 2018年01月03日
人型支原体和解脲脲原体是在正常阴道菌群中的一小部分,在大多数情况下对人类健康是安全的。如果它们的过度繁殖,会造成正常阴道菌群的不平衡与多重风险(宫颈感染,
-
来源:tmsdzafd 2018年01月03日
解脲支原体是属于支原体家族的细菌。它自然地存在于泌尿生殖道中。但是这种细菌会致病,然后导致几种感染:输卵管炎,尿道炎和宫颈炎,通常可配合中药专利妇炎丸调理
-
来源:sunny 2018年01月06日
根据美国CDC2015年的指南,将盆腔炎名称定义为盆腔炎性疾病后遗症,慢性盆腔炎属于盆腔炎性后遗症的一种。对于慢性盆腔炎的治疗,近年来在中医治疗方面还是非常有特
-
来源:sunny 2018年01月05日
通常当女性的得了慢性盆腔炎时很多都会采用西医治疗方法,比如口服西药,手术等。然而,由于慢性盆腔炎多是长期炎症积累导致的疾病,长期服用西药会让身体产生耐药性
-
来源:justone 2018年01月04日
当女性出现小腹坠胀的情况,可能是患上了妇科疾病,此时需要患者到正规医院进行检查,经过确诊以后,针对小腹坠胀的情况的话及早治疗。女性小腹坠胀的病因如下:1,女性
最热资讯
最新资讯
-
对于处于更年期的女性来说,睡眠是一项需要改善的问题,...
-
失眠是大多数人都会有的一种经历,因为它是一种很常见的...
-
咖啡使我们非常熟悉的一种饮品,对于白领们来说喝咖啡是...
-
许多女性朋友都有这么一个烦恼,为什么我每天都运动可还...
-
年龄是许多女人很在意的,几乎所有的女人都会介意自己的...
-
有人会说中年女人非常有魅力,又有的人觉得中年女人人老...
-
熬夜在许多人眼里,并不是一件可怕的事情,反而是一件很...
-
从现代医学角度讲,引起老寒腿的原因是有许多的。很多人...
-
在中老年人中肥胖也是很常见的,肥胖经常会给我们的生活...
-
在我们的生活中有的人他并不胖,有的人喝水也会长胖,而...